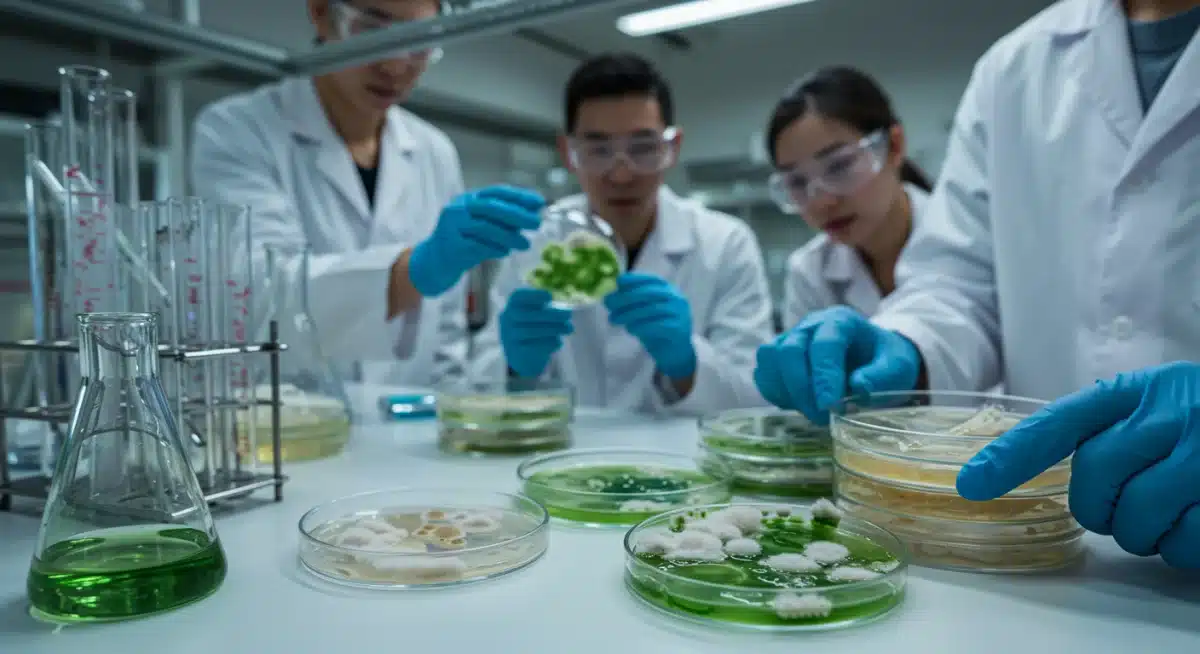
Scientists developing bio-based eco-friendly fabric innovations in a lab.

The 5 Latest Eco-Friendly Fabric Innovations for 2026: What Consumers Need to Know About Sustainable Apparel.
Latest developments on The 5 Latest Eco-Friendly Fabric Innovations for 2026: What Consumers Need to Know About Sustainable Apparel., with key facts, verified sources and what readers need to monitor next in Estados Unidos, presented clearly in Inglês (Estados Unidos) (en-US).
The 5 Latest Eco-Friendly Fabric Innovations for 2026: What Consumers Need to Know About Sustainable Apparel. is shaping today’s agenda with new details released by officials and industry sources. This update prioritizes what changed, why it matters and what to watch next, in a straightforward news format.
The Growing Imperative for Sustainable Apparel
The fashion industry faces increasing scrutiny over its environmental impact, driving a monumental shift towards sustainability. Consumers are becoming more conscious of their purchasing decisions, demanding transparency and eco-friendly alternatives from brands.
This heightened awareness creates a fertile ground for innovation, pushing textile manufacturers and designers to explore novel materials and production methods. The focus is now on reducing waste, conserving resources, and minimizing pollution throughout the entire supply chain.
As 2026 approaches, several groundbreaking eco-friendly fabric innovations are poised to redefine sustainable apparel. These developments offer promising solutions to long-standing environmental challenges, signaling a new era for fashion.
Mycelium-Based Leathers: The Next Generation of Vegan Alternatives
Mycelium, the root structure of mushrooms, is emerging as a revolutionary material for sustainable fashion. This bio-based alternative offers a compelling substitute for traditional animal leather, without the associated ethical and environmental concerns.
Cultivated in controlled environments, mycelium can be grown into sheets that mimic the texture, durability, and aesthetic of animal hide. This process requires significantly less water, land, and emits fewer greenhouse gases compared to conventional leather production.
Brands are already experimenting with mycelium leather for accessories, footwear, and garments, with widespread adoption anticipated by 2026. Consumers can expect to see more products featuring this innovative, cruelty-free material on the market.
The Science Behind Mycelium Growth
Mycelium grows by consuming agricultural waste, transforming it into a dense, interconnected network of fibers. Researchers are refining cultivation techniques to optimize material properties, such as strength, flexibility, and water resistance.
The versatility of mycelium allows for customization during the growth process, enabling manufacturers to produce materials with varied thicknesses and textures. This adaptability makes it suitable for a wide range of apparel applications, from sturdy jackets to delicate accessories.
Environmental Benefits and Market Adoption
Beyond its ethical advantages, mycelium leather significantly reduces the environmental footprint of fashion. It offers a biodegradable option that can return to the earth without harmful residues, aligning with circular economy principles.
- Reduced water consumption compared to animal leather.
- Lower greenhouse gas emissions in production.
- Biodegradable and compostable at end-of-life.
- Cruelty-free alternative for conscious consumers.
Algae-Based Fibers: From Photosynthesis to Fashion
Algae, a fast-growing aquatic organism, is being harnessed to create innovative textile fibers with remarkable sustainability credentials. This natural resource offers a scalable and environmentally friendly alternative to conventional materials.
The process involves extracting cellulose from algae and spinning it into fibers that can be woven into various fabrics. These materials often possess unique properties, including breathability and moisture-wicking capabilities, making them ideal for activewear and everyday garments.
The development of algae-based fibers represents a significant step towards decoupling fashion from petrochemicals and land-intensive crops. By 2026, these materials are expected to gain traction, offering consumers truly sustainable apparel options.
Cultivation and Production Advances
Algae can be cultivated in bioreactors, requiring minimal land and often utilizing wastewater, thereby reducing resource demands. The growth process captures carbon dioxide, contributing to a net positive environmental impact.
Researchers are focusing on optimizing fiber extraction and spinning techniques to enhance material performance and expand its application range. This includes improving dye uptake and ensuring durability for commercial use.

Sustainability Footprint and Future Potential
Algae-based textiles offer a closed-loop system, as the cultivation and processing can be designed to be highly resource-efficient. Their biodegradability further enhances their appeal as a truly eco-friendly fabric innovation.
- Carbon capture during algae growth.
- Reduced reliance on fresh water and arable land.
- Biodegradable and non-toxic properties.
- Potential for diverse textile applications.
Recycled and Upcycled Synthetics: Closing the Loop
The transformation of existing synthetic waste into new, high-performance fabrics is a critical component of sustainable apparel. Innovations in recycling and upcycling technologies are making significant strides in reducing textile waste and virgin resource consumption.
Polyester and nylon, common in activewear and outdoor gear, are now widely recycled from post-consumer plastic bottles and discarded fishing nets. Advanced processes are improving the quality and versatility of these recycled materials, making them indistinguishable from their virgin counterparts.
By 2026, consumers will find an even broader array of garments made from recycled and upcycled synthetics, from everyday fashion to specialized technical wear. This trend is crucial for establishing a circular economy within the textile industry.
Advanced Recycling Technologies
Chemical recycling methods are gaining prominence, allowing for the breakdown of synthetic fibers into their molecular components, which can then be re-polymerized into new, high-quality fibers. This overcomes some limitations of mechanical recycling, such as degradation of fiber quality over multiple cycles.
Textile-to-textile recycling is also advancing, enabling old garments to be converted directly into new fabrics, further closing the loop. These innovations are essential for managing the vast quantities of textile waste generated annually.
The Impact on Consumer Choices
The increasing availability of recycled synthetics empowers consumers to make more environmentally responsible choices without compromising on performance or style. Brands are actively promoting these materials, highlighting their contribution to waste reduction.
- Reduces plastic pollution in oceans and landfills.
- Conserves petroleum resources used in virgin synthetic production.
- Maintains high performance and durability of fabrics.
- Supports a circular economy model for textiles.
Bio-Synthetics and Plant-Based Polymers: A Hybrid Approach
Bio-synthetics, derived from renewable plant-based resources rather than fossil fuels, represent a promising hybrid solution in sustainable apparel. These materials offer the performance characteristics of traditional synthetics with a significantly reduced environmental footprint.
Innovations include polylactic acid (PLA) from corn starch, and new developments utilizing sugarcane, castor beans, or even agricultural waste. These bio-polymers can be engineered to create fabrics with diverse properties, from soft and breathable to strong and water-resistant.
As manufacturing processes become more efficient and scalable, bio-synthetics are set to become a mainstream option by 2026. They provide a vital bridge between natural fibers and high-performance synthetics, meeting a wide range of consumer needs.
Innovations in Bio-Polymer Development
Research is focused on developing bio-polymers that are fully biodegradable or compostable, addressing the end-of-life challenge of traditional synthetics. This involves engineering molecular structures that can break down safely in natural environments.
New blending techniques are also exploring combinations of bio-synthetics with natural fibers to create composite materials that leverage the best properties of both. This enhances both performance and sustainability.
Expanding Applications in Fashion
Bio-synthetics are finding applications across various apparel categories, from activewear to formal wear, due to their versatility. Their ability to mimic traditional synthetics while being more sustainable makes them highly attractive to both brands and consumers.
- Reduced reliance on fossil fuels.
- Lower carbon emissions during production.
- Potential for biodegradability and compostability.
- Versatile performance characteristics for diverse applications.
Smart Sustainable Textiles: Integrating Technology and Eco-Consciousness
The convergence of smart technology with sustainable textiles is creating a new category of eco-friendly fabric innovations for 2026. These intelligent fabrics offer enhanced functionality while adhering to rigorous environmental standards.
Examples include textiles with embedded sensors for health monitoring, self-cleaning properties that reduce the need for frequent washing, and temperature-regulating materials that minimize energy consumption for heating and cooling. The sustainability aspect comes from the materials used and the lifecycle benefits.
These advanced textiles are designed with durability and recyclability in mind, ensuring that technological integration does not compromise their environmental credentials. Consumers can expect functional, sustainable, and innovative apparel in the near future.
Sustainable Smart Material Integration
The development of smart textiles involves integrating electronics and functional components using sustainable methods and materials. This includes using conductive threads made from recycled metals or bio-based polymers, and ensuring components are easily separable for recycling.
Focus is also on minimizing energy consumption of embedded technologies and ensuring that the entire smart garment can be responsibly managed at the end of its life cycle, aligning with circular design principles.
Future Impact on Consumer Lifestyles
Smart sustainable textiles promise to revolutionize how we interact with our clothing, offering benefits that extend beyond mere aesthetics. Their ability to reduce resource consumption through features like self-cleaning or adaptive insulation will have a tangible positive impact.
- Enhanced garment functionality and longevity.
- Reduced need for frequent washing (e.g., self-cleaning fabrics).
- Energy savings through temperature-regulating properties.
- Integration of sustainable materials in technological components.
The Role of Consumers in Driving Eco-Friendly Fabric Innovations
Consumer demand plays a pivotal role in accelerating the adoption and development of eco-friendly fabric innovations. Informed purchasing decisions send clear signals to the industry, encouraging brands to invest further in sustainable practices and materials.
By actively seeking out sustainable apparel and asking questions about material sourcing and production, consumers empower the market to prioritize environmental responsibility. This collective action is essential for transforming the fashion landscape.
Understanding the benefits and limitations of various sustainable materials enables consumers to make choices that align with their values. This informed approach is crucial for fostering a truly sustainable and ethical fashion industry by 2026 and beyond.
Educating for Sustainable Choices
Access to clear and reliable information about sustainable fabrics is critical for consumers. Brands and organizations have a responsibility to provide transparent labeling and educational resources to help demystify complex textile processes.
Initiatives that highlight the environmental impact of conventional fashion versus sustainable alternatives can empower individuals to make more conscious decisions. This includes understanding certifications and ethical production standards.
Supporting Innovative Brands
Choosing brands that actively invest in and promote eco-friendly fabric innovations directly supports their efforts. Consumer loyalty to sustainable brands helps drive the economic viability of these new materials and technologies.
- Demand transparency from fashion brands.
- Prioritize garments made from certified sustainable materials.
- Support brands that invest in eco-friendly fabric innovations.
- Educate oneself on the environmental impact of clothing choices.
Challenges and Opportunities in Sustainable Apparel
While the momentum for eco-friendly fabric innovations is strong, several challenges remain in achieving widespread sustainability in apparel. These include scaling production, ensuring cost-effectiveness, and overcoming consumer skepticism.
The transition from traditional manufacturing to sustainable practices requires significant investment in research, development, and new infrastructure. Collaborations across the supply chain are essential to streamline processes and reduce costs.
Despite these hurdles, the opportunities for sustainable apparel are immense, with a growing market for environmentally conscious products. The continuous evolution of eco-friendly fabric innovations points to a more responsible and resilient fashion future.
Overcoming Production and Cost Barriers
Scaling up production of novel eco-friendly materials often faces initial cost disadvantages compared to established conventional textiles. Governments and industry consortia are exploring incentives and subsidies to bridge this gap and encourage adoption.
Improvements in manufacturing efficiency and increased demand are expected to drive down costs over time, making sustainable fabrics more competitive. This will broaden accessibility for a wider range of brands and consumers.
Ensuring Transparency and Trust
Building consumer trust requires robust certification systems and transparent reporting on the environmental impact of products. Addressing greenwashing concerns is paramount for the credibility and success of the sustainable apparel movement.
- Investment in scalable and efficient production methods.
- Collaborative efforts across the supply chain.
- Clear and verifiable sustainability certifications.
- Consumer education to combat misinformation.
| Key Innovation | Brief Description |
|---|---|
| Mycelium Leather | Vegan leather alternative from mushroom roots, reducing environmental impact. |
| Algae-Based Fibers | Textiles derived from fast-growing algae, offering eco-friendly and biodegradable options. |
| Recycled Synthetics | High-performance fabrics made from recycled plastics and textile waste, closing the loop. |
| Bio-Synthetics | Polymers derived from renewable plant sources, offering sustainable alternatives to fossil-based synthetics. |
Frequently Asked Questions About Sustainable Apparel
The main benefits include significantly reduced environmental impact, such as lower water and energy consumption, decreased pollution, and less waste. These innovations also often offer ethical advantages, like being cruelty-free, and support a circular economy by using recycled or biodegradable materials.
Consumers should look for certifications from reputable organizations, transparent labeling regarding material composition and sourcing, and brands with clear sustainability commitments. Researching the brand’s practices and understanding common sustainable fabric types like organic cotton, recycled polyester, and new bio-materials is also crucial.
While initial production costs can be higher, increased demand and scaling of manufacturing processes are expected to drive prices down. By 2026, many eco-friendly fabric innovations should become more competitive with traditional materials, making sustainable apparel more accessible to a broader consumer base.
Yes, significant research and development are focused on ensuring these materials meet or exceed the performance of conventional fabrics. Mycelium leather is designed for durability, and recycled synthetics maintain high performance. Bio-synthetics are engineered for versatility, ensuring they are suitable for various apparel needs.
Smart sustainable textiles integrate technology with eco-conscious materials to offer enhanced functionality and reduced environmental impact. Features like self-cleaning properties and temperature regulation can extend garment life and reduce resource consumption, aligning innovation with sustainability goals for 2026.
Looking Ahead: The Future of Sustainable Apparel
The landscape of sustainable apparel is rapidly evolving, driven by eco-friendly fabric innovations that promise a greener future for fashion. These developments, from mycelium leathers to algae-based fibers, represent a critical shift towards environmental responsibility.
Consumers are increasingly empowered to make impactful choices, and their demand for transparency and sustainability is a powerful catalyst for industry change. The ongoing research and scaling of these innovative materials indicate a strong trajectory towards more ethical and eco-conscious clothing options.
Monitoring these trends and supporting brands committed to these advancements will be crucial as we approach 2026. The collective effort of innovators, brands, and consumers will ultimately define the success of sustainable apparel in the years to come.





